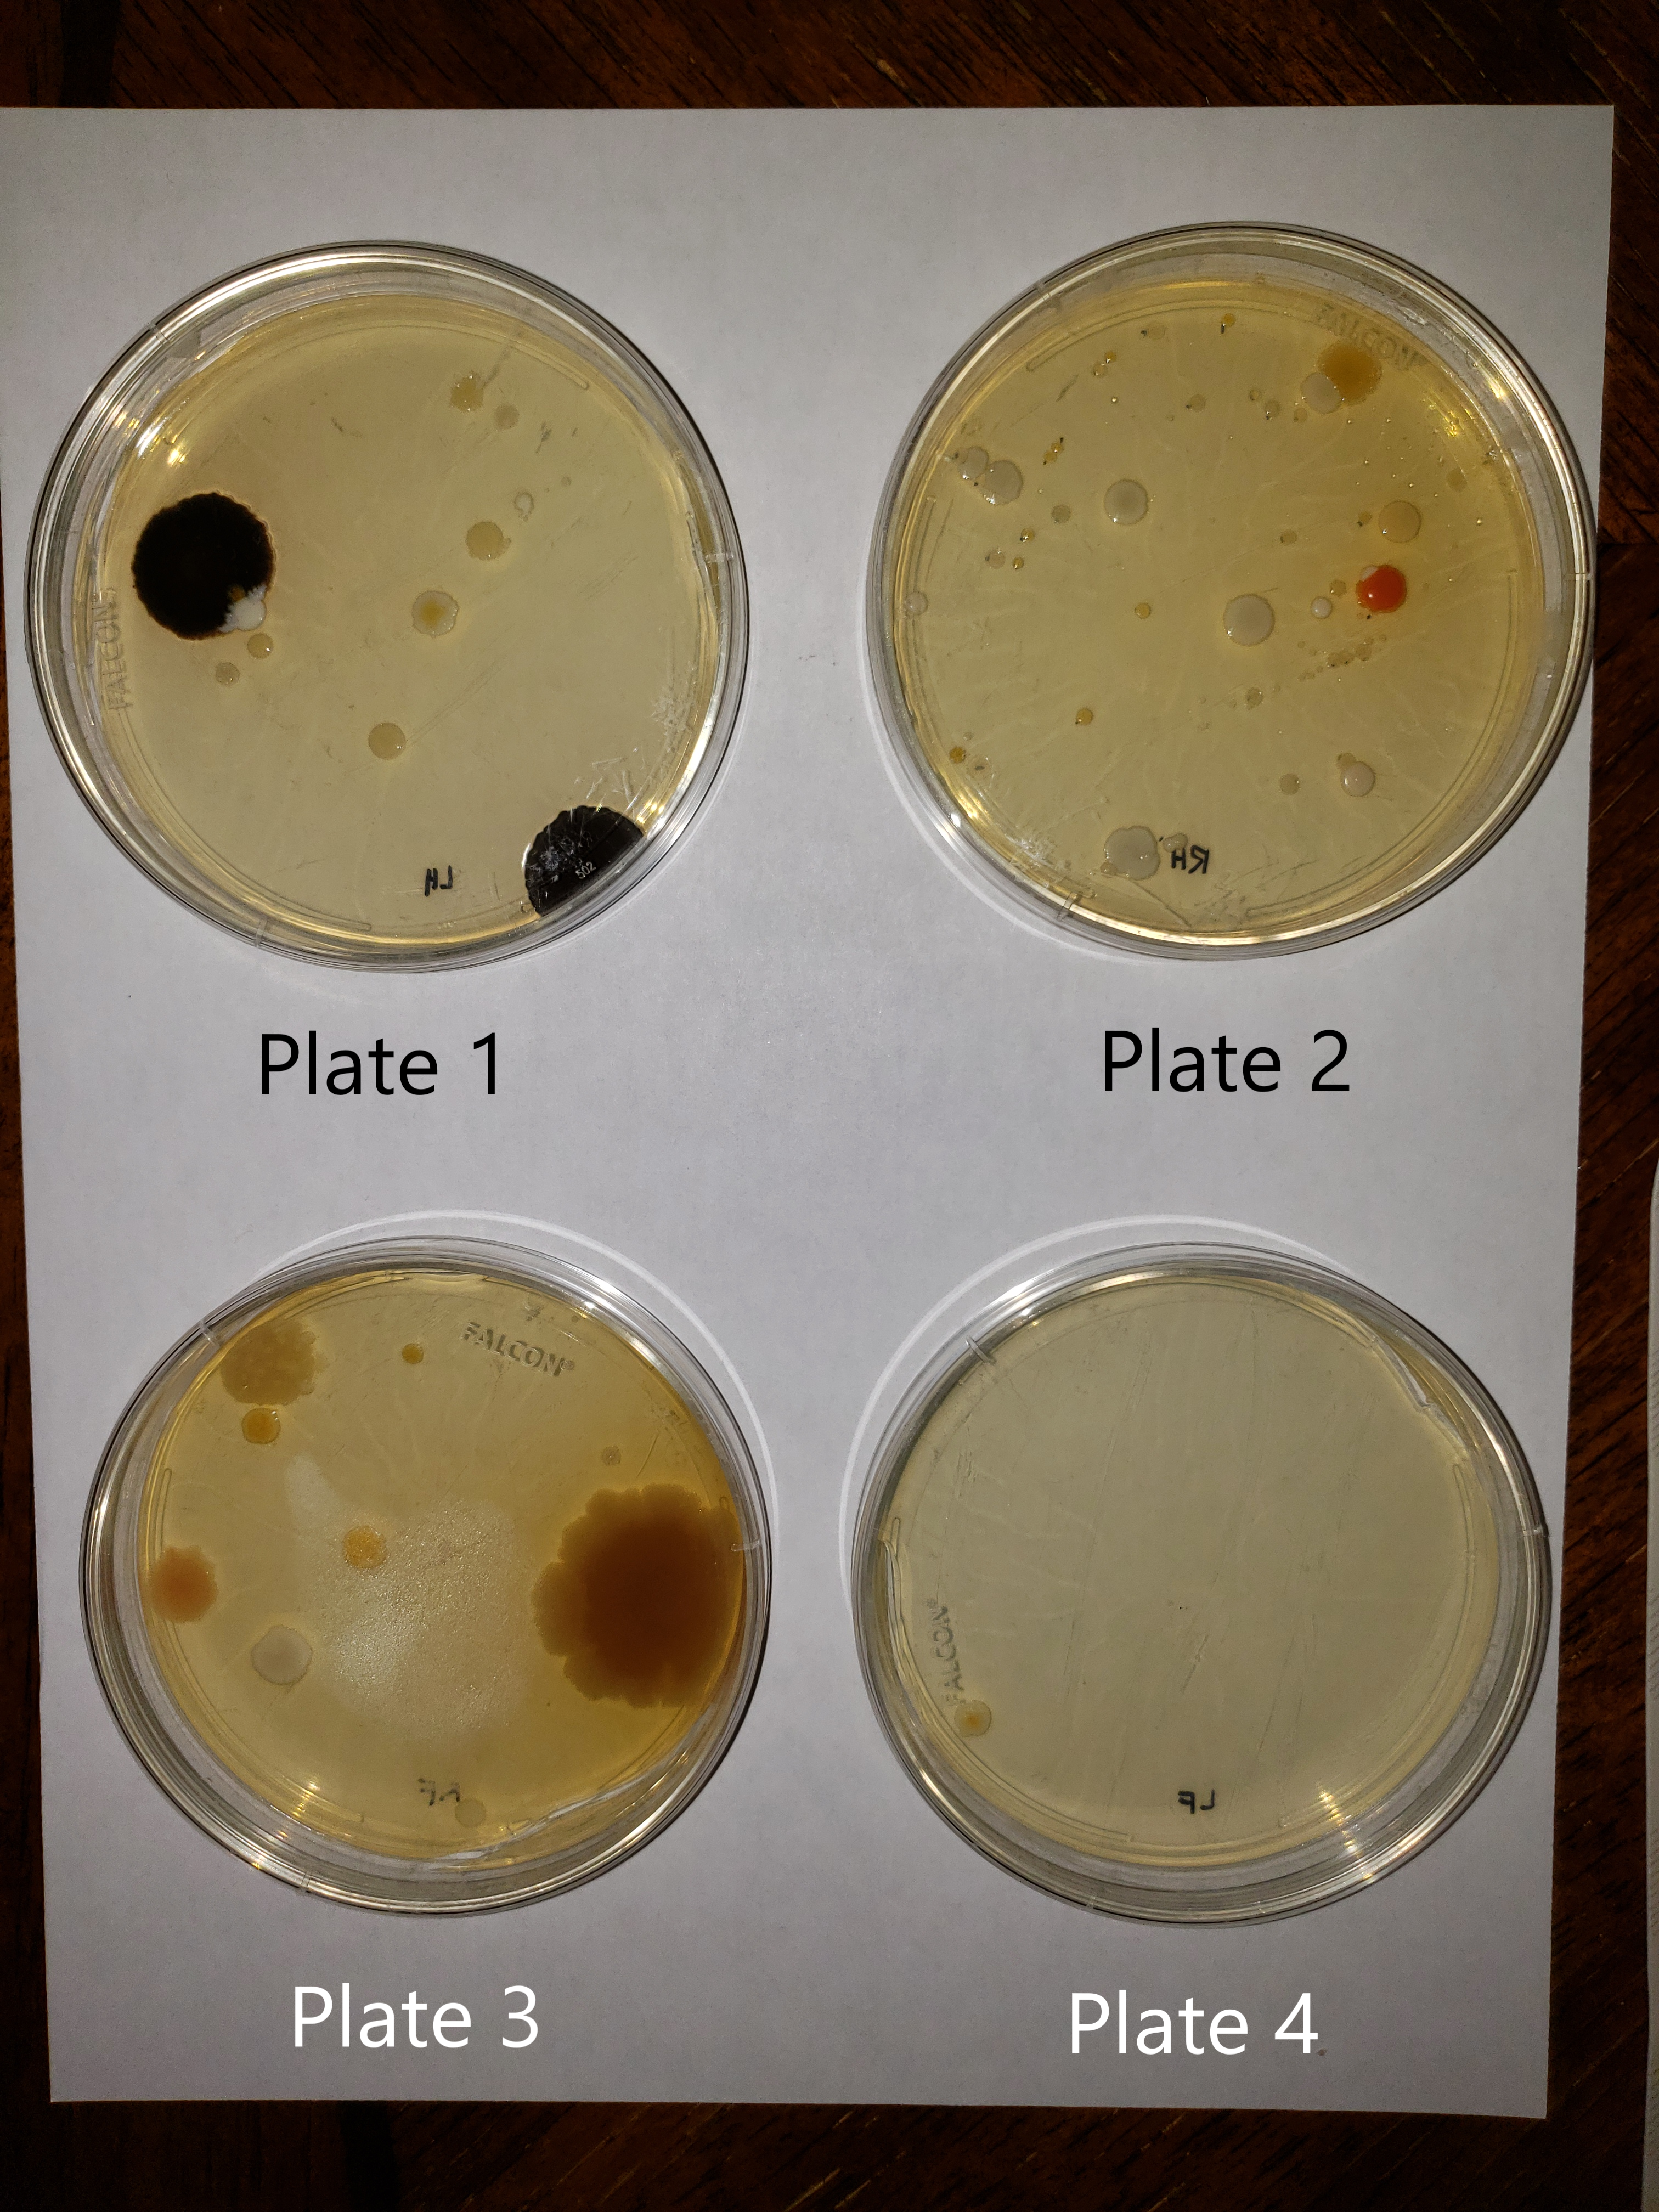
plates.png

Activity

Unknown

Microorganisms

Fungi & Lichen

Plants

Insects

Animals

Non Living

Information

Workshops

Lesson Plans
Mediashowing 3 of 3
More Posts from Chris Bascoshowing 2 of 2
Similar Foldscopers
No biography available.
No post images available.
No biography available.
No post images available.
Enseño biología a estudiantes de alto rendimiento de educación media y a docentes que cursan su especialización en Biologia
No post images available.
Mexican girl :)
Biology major student
No post images available.
Scientific artist, using art as a tool for scientific storytelling.
http://www.rebeccakonte.com/
No post images available.
No biography available.
No post images available.
No biography available.
No post images available.
No biography available.
No post images available.
No biography available.
No post images available.
No biography available.
No post images available.

 Joined Jul 05, 2021
Joined Jul 05, 2021
0 Applause
0 Applause 0 Comments
0 Comments








